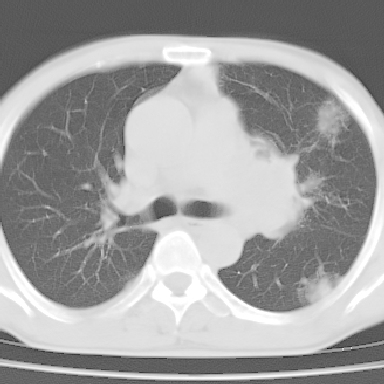
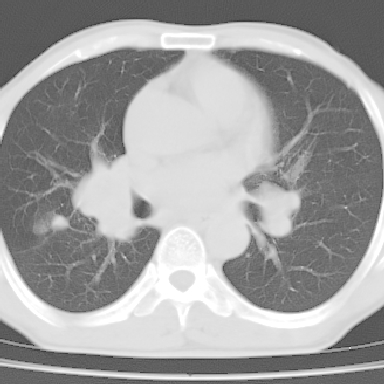

以下是引用zjzjr在2007-3-23 17:24:00的发言:[br]双侧肺门淋巴结明显肿大,以左侧为著,支气管受压变窄,肺内可见结节状及絮状高密度影,边缘模糊.考虑淋巴瘤肺内浸润.
以下是引用zjzjr在2007-3-23 17:24:00的发言:[br]双侧肺门淋巴结明显肿大,以左侧为著,支气管受压变窄,肺内可见结节状及絮状高密度影,边缘模糊.考虑淋巴瘤肺内浸润.
以下是引用zjzjr在2007-3-23 17:24:00的发言:[br]双侧肺门淋巴结明显肿大,以左侧为著,支气管受压变窄,肺内可见结节状及絮状高密度影,边缘模糊.考虑淋巴瘤肺内浸润.
以下是引用zjzjr在2007-3-23 17:24:00的发言:[br]双侧肺门淋巴结明显肿大,以左侧为著,支气管受压变窄,肺内可见结节状及絮状高密度影,边缘模糊.考虑淋巴瘤肺内浸润.
| 欢迎光临 医影在线 (http://bbs.radida.com/bbs/) | Powered by Discuz! X3.2 |